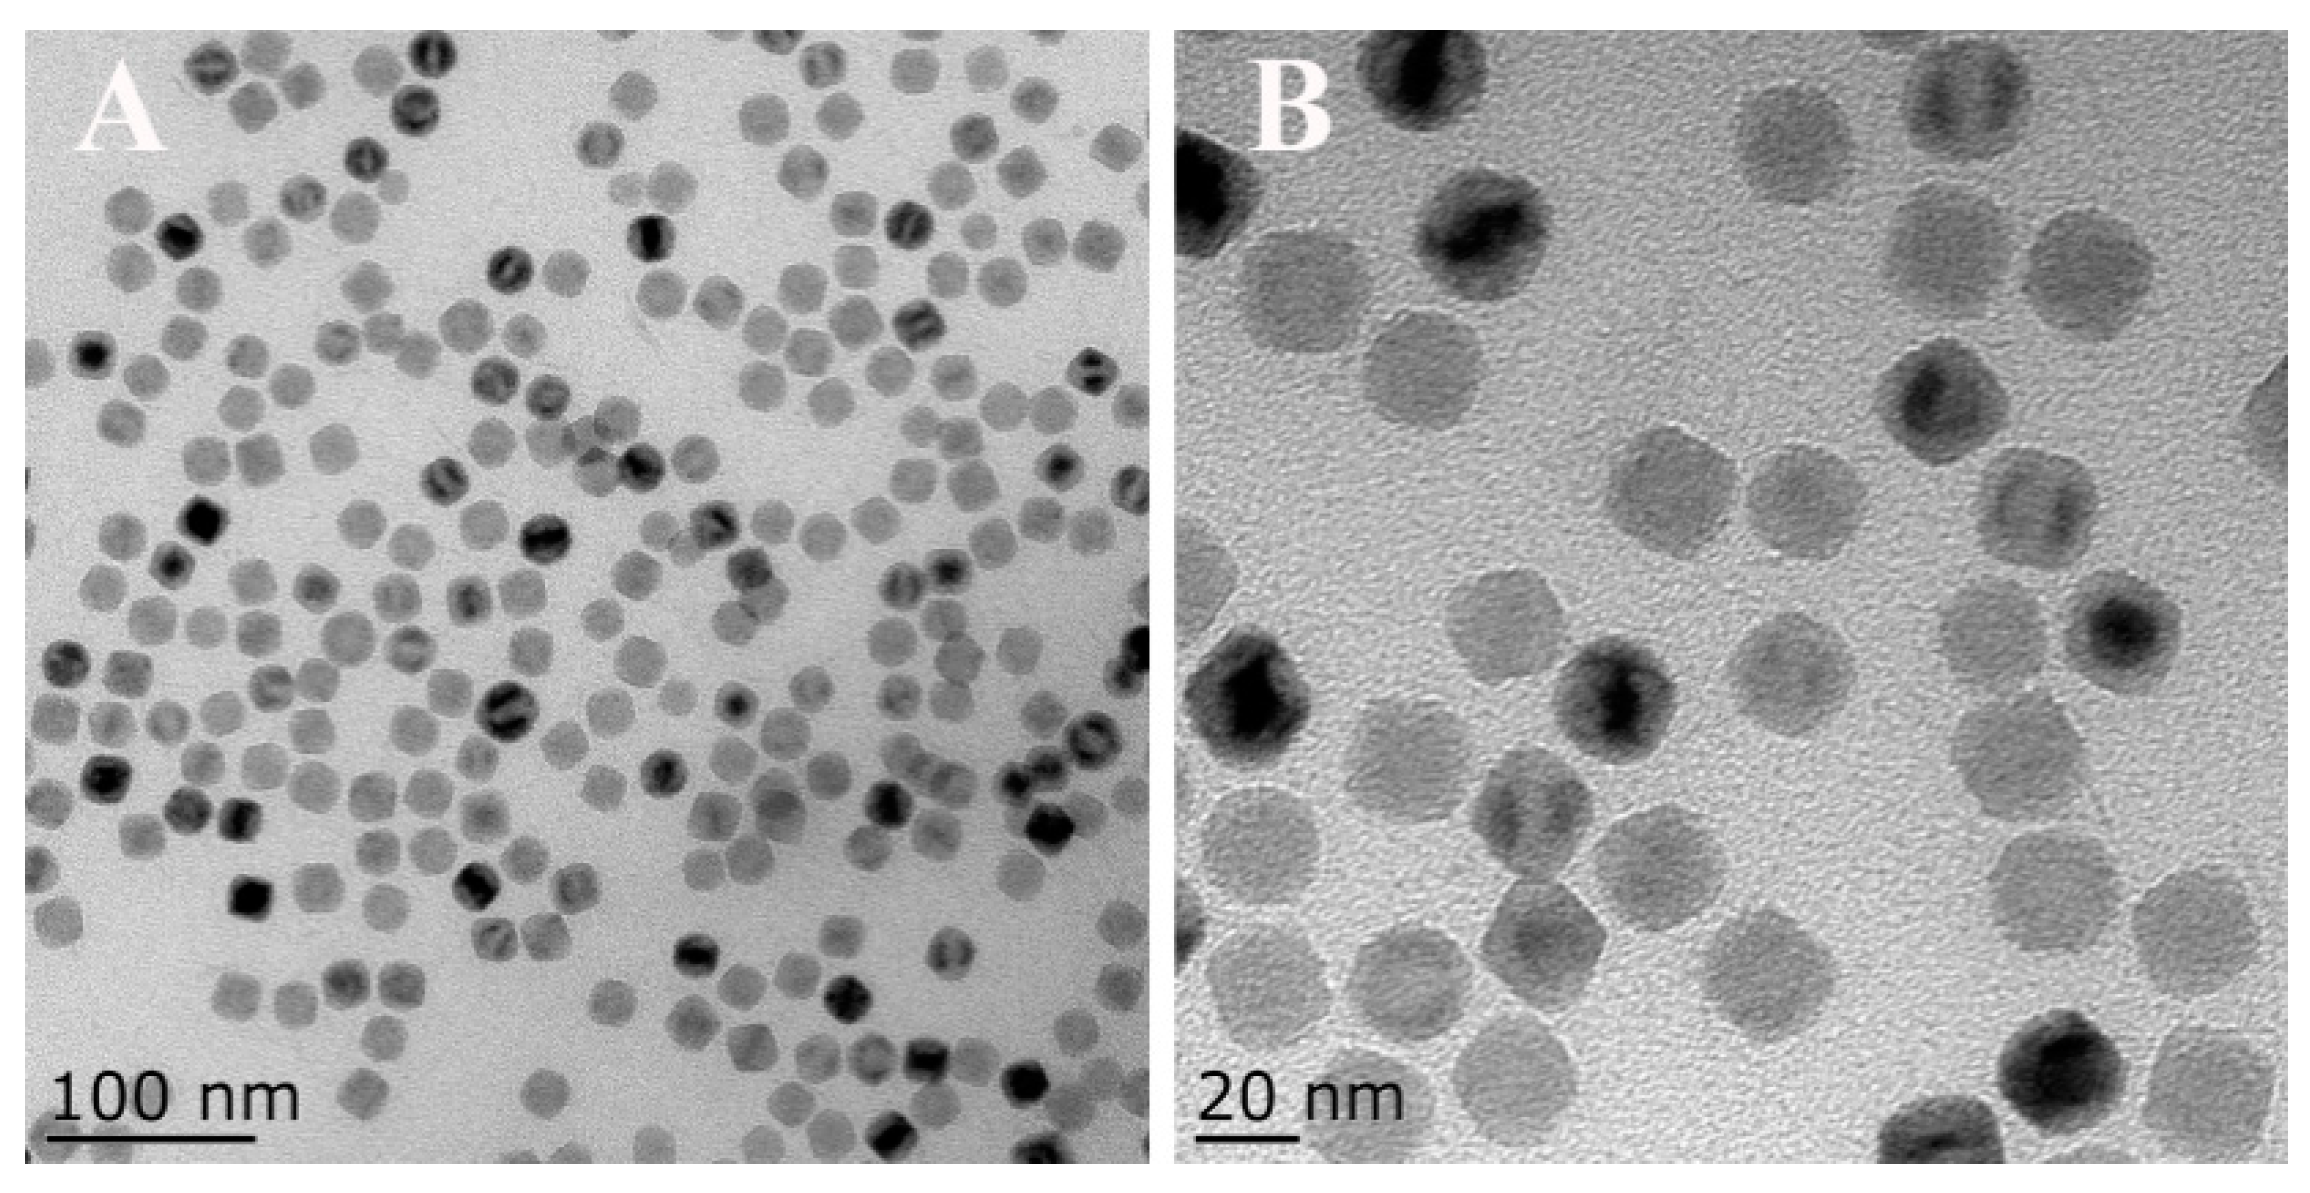
Sensors 18 02537 g002

An Electrochemiluminescence Sensor Based on Nafion/Magnetic Fe3O4 Nanocrystals Modified Electrode for the Determination of Bisphenol A in Environmental Water Samples
Abstract
:1. Introduction
2. Materials and Methods
2.1. Chemicals and Materials
2.2. Synthesis of Fe3O4-NCs
2.3. Fabrication of Nafion/Fe3O4-NCs-Coated GCE
2.4. ECL Measurement
2.5. Characterization of the ECL Sensor
2.6. BPA Determination
3. Results and Discussion
3.1. Characterization of Magnetic Fe3O4-NCs
3.2. Electrochemistry and ECL Behavior of Nafion/Fe3O4-NCs/GCE
3.3. Optimization of ECL Reaction Conditions
3.4. Quenching Efficiency and Stability
3.5. Real Sample Analysis
4. Conclusions
Author Contributions
Funding
Conflicts of Interest
References
- Lopardo, L.; Adams, D.; Cummins, A.; Kasprzyk-Hordern, B. Verifying community-wide exposure to endocrine disruptors in personal care products—In quest for metabolic biomarkers of exposure via in vitro studies and wastewater-based epidemiology. Water Res. 2018, 143, 117–126. [Google Scholar] [CrossRef] [PubMed]
- Ragavan, K.V.; Rastogi, N.K.; Thakur, M.S. Sensors and biosensors for analysis of bisphenol-A. TrAC Trends Anal. Chem. 2013, 52, 248–260. [Google Scholar] [CrossRef]
- Devi, P.G.; Chakraborty, P.K.; Dasgupta, D. Inhibition of a Zn(II)-containing enzyme, alcohol dehydrogenase, by anticancer antibiotics, mithramycin and chromomycin A3. J. Biol. Inorg. Chem. 2009, 14, 347–359. [Google Scholar] [CrossRef] [PubMed]
- Lee, H.B.; Peart, T.E.; Gris, G.; Chan, J. Endocrine-disrupting chemicals in industrial wastewater samples in Toronto, Ontario. Water Qual. Res. J. 2002, 37, 459–472. [Google Scholar] [CrossRef]
- Shafei, A.E.; Ramzy, M.M.; Hegazy, A.I.; Husseny, A.K.; EL-hadary, U.G.; Taha, M.M.; Mosa, A.A. The molecular mechanisms of action of the endocrine disrupting chemical Bisphenol A in the development of cancer. Gene 2018, 647, 235–243. [Google Scholar] [CrossRef] [PubMed]
- Di Donato, M.; Cernera, G.; Giovannelli, P.; Galasso, G.; Bilancio, A.; Migliaccio, A.; Castoria, G. Recent advances on bisphenol-A and endocrine disruptor effects on human prostate cancer. Mol. Cell Endocrinol. 2017, 457, 35–42. [Google Scholar] [CrossRef] [PubMed]
- Lang, I.A.; Galloway, T.S.; Scarlett, A.; Henley, W.E. Association of urinary bisphenol A concentration with medical disorders and laboratory abnormalities in adults. J. Am. Med. Assoc. 2008, 300, 1303–1310. [Google Scholar] [CrossRef] [PubMed]
- Martín, J.; Santos, J.L.; Aparicio, I.; Alonso, E. Analytical method for biomonitoring of endocrine-disrupting compounds (bisphenol A, parabens, perfluoroalkyl compounds and a brominated flame retardant) in human hair by liquid chromatography-tandem mass spectrometry. Anal. Chim. Acta 2016, 945, 95–101. [Google Scholar] [CrossRef] [PubMed]
- Pérez, R.A.; Albero, B.; Tadeo, J.L.; Sánchez-Brunete, C. Determination of endocrine-disrupting compounds in water samples by magnetic nanoparticle-assisted dispersive liquid-liquid microextraction combined with gas chromatography-tandem mass spectrometry. Anal. Bioanal. Chem. 2016, 408, 8013–8023. [Google Scholar] [CrossRef] [PubMed]
- Li, J.; Lu, J.X.; Qiao, X.G.; Xu, Z.X. A study on biomimetic immunoassay-capillary electrophoresis method based on molecularly imprinted polymer for determination of trace trichlorfon residue in vegetables. Food Chem. 2017, 221, 1285–1290. [Google Scholar] [CrossRef] [PubMed]
- Yu, C.M.; Gou, L.L.; Zhou, X.H.; Bao, N.; Gu, H.Y. Chitosan-Fe3O4 nanocomposite based electrochemical sensors for the determination of bisphenol A. Electrochim. Acta 2011, 56, 9056–9063. [Google Scholar] [CrossRef]
- Yin, H.S.; Zhou, Y.L.; Ai, S.Y.; Han, R.X.; Tang, T.T.; Zhu, L.S. Electrochemical behavior of bisphenol A at glassy carbon electrode modified with gold nanoparticles; silk fibroin; and PAMAM dendrimers. Microchim. Acta 2010, 170, 99–105. [Google Scholar] [CrossRef]
- Li, Q.F.; Ren, S.Y.; Wang, Y.; Bai, J.L.; Peng, Y.; Ning, B.A.; Lyu, Q.J.; Gao, Z.X. Efficient detection of environmental estrogens Bisphenol A and estradiol by sensing system based on AuNP-AuNP-UCNP triple structure. Chin. J. Anal. Chem. 2018, 46, 486–492. [Google Scholar] [CrossRef]
- Zhou, Y.; Wang, H.J.; Zhuo, Y.; Chai, Y.Q.; Yuan, R. Highly efficient electrochemiluminescent silver nanoclusters/titanium oxide nanomaterials as a signal probe for ferrocene-driven light switch bioanalysis. Anal. Chem. 2017, 89, 3732–3738. [Google Scholar] [CrossRef] [PubMed]
- Kitte, S.A.; Gao, W.; Zholudov, Y.T.; Qi, L.; Nsabimana, A.; Liu, Z.; Xu, G. Stainless steel electrode for sensitive luminol electrochemiluminescent detection of H2O2, glucose, and glucose oxidase activity. Anal. Chem. 2017, 89, 9864–9869. [Google Scholar] [CrossRef] [PubMed]
- Wu, F.F.; Zhou, Y.; Wang, J.X.; Zhuo, Y.; Yuan, R.; Chai, Y.Q. A novel electrochemiluminescence immunosensor based on Mn doped Ag2S quantum dots probe for laminin detection. Sens. Actuators B Chem. 2017, 243, 1067–1074. [Google Scholar] [CrossRef]
- Fang, C.; Zheng, L.J.; Zhai, S.Y.; Tu, Y.F. An electrochemiluminescent method to detect a dipeptide related to diabetes. Chin. J. Anal. Chem. 2017, 45, 1951–1955. [Google Scholar]
- Wang, K.; Wei, X.H.; Tu, Y.F. Strong enhancement of the electrochemiluminescence of luminol by AuAg and PtAg alloy nanoclusters, and its sensitization by phenolic artificial oestrogens. Microchim. Acta 2014, 181, 1223–1230. [Google Scholar] [CrossRef]
- Li, H.F.; Xie, C.G.; Fu, X.C. Electrochemiluminescence sensor for sulfonylurea herbicide with molecular imprinting core-shell nanoparticles/chitosan composite film modified glassy carbon electrode. Sens. Actuators B Chem. 2013, 181, 858–866. [Google Scholar] [CrossRef]
- Yang, Y.Y.; Zhang, H.; Huang, C.S.; Jia, N.Q. MWCNTs-PEI composites-based electrochemical sensor for sensitive detection of bisphenol A. Sens. Actuators B Chem. 2016, 235, 408–413. [Google Scholar] [CrossRef]
- Yang, L.L.; Zhang, Y.; Li, R.B.; Lin, C.Y.; Guo, L.H.; Qiu, B.; Lin, Z.Y.; Chen, G.N. Electrochemiluminescence biosensor for ultrasensitive determination of Ochratoxin A in corn samples based on aptamer and hyperbranched rolling circle amplification. Biosens. Bioelectron. 2015, 70, 268–274. [Google Scholar] [CrossRef] [PubMed]
- Jie, G.F.; Yuan, J.X. Novel magnetic Fe3O4@CdSe composite quantum dot-based electrochemiluminescence detection of thrombin by a multiple DNA cycle amplification strategy. Anal. Chem. 2012, 84, 2811–2817. [Google Scholar] [CrossRef] [PubMed]
- Guan, G.; Yang, L.; Mei, Q.; Zhang, K.; Zhang, Z.; Han, M.Y. Chemiluminescence switching on peroxidase-like Fe3O4 nanoparticles for selective detection and simultaneous determination of various pesticides. Anal. Chem. 2012, 84, 9492–9497. [Google Scholar] [CrossRef] [PubMed]
- Tsai, H.Y.; Hsu, C.F.; Chiu, I.W.; Fuh, C.B. Detection of C-reactive protein based on immunoassay using antibody-conjugated magnetic nanoparticles. Anal. Chem. 2007, 79, 8416–8419. [Google Scholar] [CrossRef] [PubMed]
- Wang, S.F.; Tan, Y.M.; Zhao, D.M.; Liu, G.D. Amperometric tyrosinase biosensor based on Fe3O4 nanoparticles-chitosan nanocomposite. Biosens. Bioelectron. 2008, 23, 1781–1787. [Google Scholar] [CrossRef] [PubMed]
- Wang, Y.F.; Zhu, Z.W.; Xu, F.; Wei, X.L. One-pot reaction to synthesize superparamagnetic iron oxide nanoparticles by adding phenol as reducing agent and stabilizer. J. Nanopart. Res. 2012, 14, 755. [Google Scholar] [CrossRef]
- Xu, S.J.; Liu, Y.; Wang, T.H.; Li, J.H. Positive potential operation of a cathodic electrogenerated chemiluminescence immunosensor based on luminol and graphene for cancer biomarker detection. Anal. Chem. 2011, 83, 3817–3823. [Google Scholar] [CrossRef] [PubMed]
- Hou, C.; Tang, W.X.; Zhang, C.; Wang, Y.F.; Zhu, N.N. A novel and sensitive electrochemical sensor for bisphenol A determination based on carbon black supporting ferroferric oxide nanoparticles. Electrochim. Acta 2014, 144, 324–331. [Google Scholar] [CrossRef]
- Wu, Z.; Hu, J.; Zeng, T.; Zhang, Z.L.; Chen, J.J.; Wong, G.; Qiu, X.G.; Liu, W.J.; Gao, G.F.; Bi, Y.B.; et al. Ultrasensitive ebola virus detection based on electroluminescent nanospheres and immunomagnetic separation. Anal. Chem. 2017, 89, 2039–2048. [Google Scholar] [CrossRef] [PubMed]
- Li, J.; Xie, H.Q.; Chen, L.F. A sensitive hydrazine electrochemical sensor based on electrodeposition of gold nanoparticles on choline film modified glassy carbon electrode. Sens. Actuators B Chem. 2011, 153, 239–245. [Google Scholar] [CrossRef]
- Zhu, S.; Lin, X.; Ran, P.Y.; Xia, Q.; Yang, C.C.; Ma, J.; Fu, Y.Z. A novel luminescence-functionalized metal-organic framework nanoflowers electrochemiluminesence sensor via “on-off” system. Biosens. Bioelectron. 2017, 91, 436–440. [Google Scholar] [CrossRef] [PubMed]
- Hong, L.R.; Zhao, J.; Lei, Y.M.; Yuan, R.; Zhuo, Y. Efficient electrochemiluminescence from Ru(bpy)32+ enhanced by three-layer porous Fe3O4@SnO2@Au nanoparticles for label-free and sensitive bioanalysis. Electrochim. Acta 2017, 241, 291–298. [Google Scholar] [CrossRef]
- Dong, Y.P.; Wang, J.; Peng, Y.; Zhu, J.J. Electrogenerated chemiluminescence resonance energy transfer between luminol and CdS/graphene nanocomposites and its sensing application. J. Electroanal. Chem. 2016, 781, 109–113. [Google Scholar] [CrossRef]
- Rizwan, M.; Mohd-naim, N.F.; Ahmed, M.U. Trends and advances in electrochemiluminescence nanobiosensors. Sensors 2018, 18, 166. [Google Scholar] [CrossRef] [PubMed]
- Zhou, C.S.; Liu, Z.; Dai, J.Y.; Xiao, D. Electrospun Ru (bpy)32+-doped nafion nanofibers for electrochemiluminescence sensing. Analyst 2010, 135, 1004–1009. [Google Scholar] [CrossRef] [PubMed]
- Lin, Y.; Liu, K.; Liu, C.; Yin, L.; Kang, Q.; Li, L.; Li, B. Electrochemical sensing of bisphenol A based on polyglutamic acid/amino-functionalised carbon nanotubes nanocomposite. Electrochim. Acta 2014, 133, 492–500. [Google Scholar] [CrossRef]
- Zheng, Z.; Du, Y.; Wang, Z.; Feng, Q.; Wang, C. Pt/grapheme-CNTs nanocomposite based electrochemical sensors for the determination of endocrine disruptor bisphenol A in thermal printing papers. Analyst 2013, 13, 693–701. [Google Scholar]
- Guo, W.; Zhang, A.; Zhang, X.; Huang, C.; Yang, D.; Jia, N. Multiwalled carbon nanotubes/gold nanocomposites-based electrochemiluminescent sensor for sensitive determination of Bisphenol A. Anal. Bioanal. Chem. 2016, 408, 7173–7180. [Google Scholar] [CrossRef] [PubMed]
- Portaccio, M.; Tuoro, D.D.; Arduini, F.; Moscone, D.; Cammarota, M.; Mita, D.G.; Lepore, M. Laccase biosensor based on screen-printed electrode modified with thionine-carbon black nanocomposite for Bisphenol A detection. Electrochim. Acta 2013, 109, 340–347. [Google Scholar] [CrossRef]
- Niu, X.; Yang, W.; Wang, G.; Ren, J.; Guo, H.; Gao, J. A novel electrochemical sensor of bisphenol A based on stacked graphene nanofibers/gold nanoparticles composite modified glassy carbon electrode. Electrochim. Acta 2013, 98, 167–175. [Google Scholar] [CrossRef]

| Type of Water | Added (mg/L) | Founded (mg/L) | RSD (%) | Recovery (%) |
|---|---|---|---|---|
| River | 0.01 | 0.0102 | 2.5 | 100.3 |
| 0.10 | 0.096 | 4.6 | 96.0 | |
| 0.20 | 0.202 | 4.5 | 101.2 | |
| Tap water | 0.10 | 0.099 | 4.8 | 99.0 |
| 1.00 | 1.050 | 4.6 | 105.0 | |
| 5.00 | 4.970 | 2.5 | 99.4 |
| Modified Electrode | Method | Linear Range (mg/kg, L) | LOD (mg/kg, L) | Recovery (%) |
|---|---|---|---|---|
| PGA/MWCNT-NH2/GCE [36] | EC | 0.02–2.28 | 4.6 × 10−3 | 95.0–108.0 |
| Pt/GR-CNTs/GCE [37] | EC | 0.01–2.28 | 9.6 × 10−3 | 96.1–106.7 |
| Chitosan/MWCNTs-Au/GCE [38] | ECL | 0.06–22.8 | 18.9 × 10−3 | 95.6–105.0 |
| Boron-doped diamond electrode [39] | EC | 0.1–1.2 | 50.0 × 10−3 | 90.0–120.0 |
| AuNPs/SGNF/GCE [40] | EC | 0.02–57 | 8.0 × 10−3 | 98.4–102.1 |
| This work | ECL | 0.01–50.0 | 0.66 × 10−3 | 96.0–105.0 |
© 2018 by the authors. Licensee MDPI, Basel, Switzerland. This article is an open access article distributed under the terms and conditions of the Creative Commons Attribution (CC BY) license (http://creativecommons.org/licenses/by/4.0/).
Share and Cite
Chai, J.; Yu, X.; Zhao, J.; Sun, A.; Shi, X.; Li, D. An Electrochemiluminescence Sensor Based on Nafion/Magnetic Fe3O4 Nanocrystals Modified Electrode for the Determination of Bisphenol A in Environmental Water Samples. Sensors 2018, 18, 2537. https://doi.org/10.3390/s18082537
Chai J, Yu X, Zhao J, Sun A, Shi X, Li D. An Electrochemiluminescence Sensor Based on Nafion/Magnetic Fe3O4 Nanocrystals Modified Electrode for the Determination of Bisphenol A in Environmental Water Samples. Sensors. 2018; 18(8):2537. https://doi.org/10.3390/s18082537
Chicago/Turabian StyleChai, Jiye, Xinru Yu, Jian Zhao, Aili Sun, Xizhi Shi, and Dexiang Li. 2018. "An Electrochemiluminescence Sensor Based on Nafion/Magnetic Fe3O4 Nanocrystals Modified Electrode for the Determination of Bisphenol A in Environmental Water Samples" Sensors 18, no. 8: 2537. https://doi.org/10.3390/s18082537
APA StyleChai, J., Yu, X., Zhao, J., Sun, A., Shi, X., & Li, D. (2018). An Electrochemiluminescence Sensor Based on Nafion/Magnetic Fe3O4 Nanocrystals Modified Electrode for the Determination of Bisphenol A in Environmental Water Samples. Sensors, 18(8), 2537. https://doi.org/10.3390/s18082537
